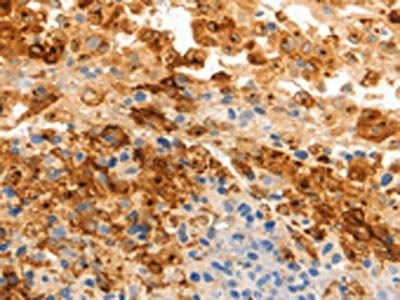

SPP1 Antibody
-
中文名稱:SPP1兔多克隆抗體
-
貨號:CSB-PA297038
-
規格:¥1100
-
圖片:
-
The image on the left is immunohistochemistry of paraffin-embedded Human ovarian cancer tissue using CSB-PA297038(SPP1 Antibody) at dilution 1/20, on the right is treated with fusion protein. (Original magnification: ×200)
-
Gel: 10%SDS-PAGE, Lysate: 40 μg, Lane: OP9 cells, Primary antibody: CSB-PA297038(SPP1 Antibody) at dilution 1/250, Secondary antibody: Goat anti rabbit IgG at 1/8000 dilution, Exposure time: 30 seconds
-
-
其他:
產品詳情
-
Uniprot No.:
-
基因名:
-
別名:BNSP antibody; Bone sialoprotein 1 antibody; Bone sialoprotein I antibody; BSP I antibody; BSPI antibody; Early T lymphocyte activation 1 antibody; ETA 1 antibody; ETA1 antibody; MGC110940 antibody; Nephropontin antibody; OPN antibody; Osteopontin antibody; osteopontin/immunoglobulin alpha 1 heavy chain constant region fusion protein antibody; OSTP_HUMAN antibody; PSEC0156 antibody; secreted phosphoprotein 1 (osteopontin bone sialoprotein I early T lymphocyte activation 1) antibody; secreted phosphoprotein 1 (osteopontin, bone sialoprotein I, early T-lymphocyte activation 1) antibody; Secreted phosphoprotein 1 antibody; SPP 1 antibody; SPP-1 antibody; SPP1 antibody; SPP1/CALPHA1 fusion antibody; Urinary stone protein antibody; Uropontin antibody
-
宿主:Rabbit
-
反應種屬:Human
-
免疫原:Fusion protein of Human SPP1
-
免疫原種屬:Homo sapiens (Human)
-
標記方式:Non-conjugated
-
抗體亞型:IgG
-
純化方式:Antigen affinity purification
-
濃度:It differs from different batches. Please contact us to confirm it.
-
保存緩沖液:-20°C, pH7.4 PBS, 0.05% NaN3, 40% Glycerol
-
產品提供形式:Liquid
-
應用范圍:ELISA,WB,IHC
-
推薦稀釋比:
Application Recommended Dilution ELISA 1:1000-1:2000 WB 1:200-1:1000 IHC 1:25-1:100 -
Protocols:
-
儲存條件:Upon receipt, store at -20°C or -80°C. Avoid repeated freeze.
-
貨期:Basically, we can dispatch the products out in 1-3 working days after receiving your orders. Delivery time maybe differs from different purchasing way or location, please kindly consult your local distributors for specific delivery time.
-
用途:For Research Use Only. Not for use in diagnostic or therapeutic procedures.
相關產品
靶點詳情
-
功能:Major non-collagenous bone protein that binds tightly to hydroxyapatite. Appears to form an integral part of the mineralized matrix. Probably important to cell-matrix interaction.; Acts as a cytokine involved in enhancing production of interferon-gamma and interleukin-12 and reducing production of interleukin-10 and is essential in the pathway that leads to type I immunity.
-
基因功能參考文獻:
- Plasma OPN levels were associated with the presence and severity of diabetic retinopathy in Asians with type 2 diabetes. PMID: 29463954
- Study demonstrated that osteopontin exerts an important role in the monocytes/macrophage phenotypic differentiation from hypertensive patients with vascular calcification. PMID: 28091516
- The expression of OPN was high in endometrium in secretory phase and in vitro decidualized endometrial stromal cells. Further analysis confirmed that OPN expression was upregulated by cAMP and C/EBPbeta signal pathway, while downregulated by miR181b. Increased OPN expression could promote the expression of decidualization-related and angiogenesis-related genes PMID: 29420252
- Results of the study showed that low urinary OPN levels were correlated with increased kidney stone risk, and dietary habits can affect urinary OPN level PMID: 30114399
- The serum levels of cystatin C and urine NGAL, urine OPN can be used as a good marker for assessing the renal effect of obesity which can lead end stage renal disease in pediatric population. PMID: 30035656
- novel 9175th- (exon 7) position polymorphism of OPN and rs17524488 were related to susceptibility to ankylosing spondylitis in a Chinese population PMID: 29581970
- Over-expressed and hypo-methylated SPP1 gene is associated with hepatocellular carcinoma. PMID: 27760737
- Serum osteopontin concentrations were increased in acute pancreatitis (AP) compared with follow-up 3 months after discharge. PMID: 29424811
- Our data provide evidence that leptin-mediated OPN upregulation promote TH2 inflammation in AR and this process is achieved through the alpha4 integrin and PI3K/AKT signaling pathways. PMID: 29885866
- miR-129-5p level was decreased in fibrotic liver of human, and reduced by rOPN treatment. In contrast, miR-129-5p was induced in HSCs transfected by OPN siRNA. These data suggested that OPN induces Col 1 expression via suppression of miR-129-5p in hepatic stellate cells. PMID: 29196165
- High circulating osteopontin levels predict major adverse cardiovascular events in patients with severe carotid artery stenosis. PMID: 29317141
- High SPP1 Expression is associated with Hepatocellular Carcinomas. PMID: 29693976
- Serum OPN and DKK1 levels of hepatocellular carcinoma patients could be considered as novel biomarkers showing prognostic significance after hepatectomy based on long-term survival data PMID: 29753515
- Upregulation of ADIPOR1 and SPP1, among the adipokine gene family, in cancer tissue is associated with poor survival in CRC, suggesting a potential mechanism linking obesity and colorectal cancer. PMID: 29761507
- Review/Meta-analysis: report a significantly higher circulating OPN level in systemic lupus erythematosus patients, a trend of positive correlation between OPN levels and SLE activity, and a significant association between OPN 1239 C/A and 9250 C/T polymorphisms, and SLE development. PMID: 27307447
- OPN is not only the pivotal protein controlling fibrosis, but may also serve as a biomarker associated with prognosis. PMID: 29120858
- Our data show that the ability of AML cells to constitutively release high levels of osteopontin is associated with a favorable prognosis, and this is different from previous studies of osteopontin mRNA levels. PMID: 27739925
- First report of OPN cleavage in THP-1 macrophages after PMA (phorbol 12-myristate 13-acetate) stimulation, and of enhanced cleavage induced by BCG infection (bovine tuberculosis). PMID: 29385060
- The results suggest that OPN, MMP9 and S100A8 all play a significant role in bladder cancer progression and are potential prognostic markers and therapeutic targets in bladder cancer PMID: 29209142
- We demonstrated an important effect of the SPP1 rs4754 on subclinical markers of carotid atherosclerosis in subjects with T2DM; however, as demonstrated by the multiple linear regression analysis, neither rs4754 nor rs28357094 had an important impact on the progression of subclinical markers of carotid atherosclerosis in subjects with T2DM. PMID: 28990744
- these results showed that expression of tear OPN protein by perennial allergic conjunctivitis patients increased significantly compared with controls or seasonal allergic conjunctivitis patients out of the pollen season PMID: 29279263
- The study revealed an enhanced sensitivity of aortic valve interstitial cells to osteogenic inductors in aortic stenosis patients, which indicates probable implication of OPN, OPG, and BMP2 genes in pathogenesis of aortic valve calcification. PMID: 29308559
- Carriers of the risky genotype or haplotype also had increased gastric OPN expression (p = 0.038) and inflammation (p = 0.007). SPP1 polymorphisms predispose to intestinal metaplasia development in H. pylori infected males. PMID: 28685609
- Respiratory syncytial virus infection leads to increased OPN expression.IL-1beta is involved in the regulation of OPN levels during respiratory syncytial virus infection. PMID: 29677209
- plasma level increases in pregnancy independently of asthma PMID: 29200898
- Methylglyoxal-bis-guanylhydrazone may have potential therapeutic utility in reducing or normalizing OPN levels and regulating monocyte activation in diseases that involve chronic inflammation. PMID: 29538412
- These results might be considered a useful starting point to validate OPN as a prognostic and diagnostic marker of hepatocellular carcinoma. PMID: 28711012
- study demonstrates that the OPN gene SNP rs1126616 is statistically associated with cerebral palsy. PMID: 27114095
- LAMP3 promotes the invasion of osteosarcoma cells via SPP1 signaling. PMID: 28849219
- Extended liver surgery is the only potentially curative treatment for patients with cholangiocarcinoma (CCA/biliary cancer), but it is currently unclear which patients benefit most from surgery. Detecting serum levels of osteopontin - a specific secreted glycoprotein involved in multiple diseases - in CCA patients might help to identify those patients that particularly benefit from tumour resection. PMID: 28668580
- MALAT1 could directly bind to miR-127-5p to inhibit its expression, so as to rescue OPN expression and promote chondrocyte proliferation through PI3K/Akt pathway. PMID: 28590075
- A linear negative correlation between serum OPN and total bone mineral density (BMD) of Type I diabetes mellitus patients compared to control group was noticed, indicating that the amount of serum OPN could be effective on BMD and a good predicting factor for osteoporosis PMID: 28499311
- OPN regulates CYP7A1 levels and the metabolic fate of liver acetyl-CoA as a result of CHOL and PC metabolism interplay PMID: 28754826
- these findings demonstrated that OPN and VEGF were overproduced in nasal polyps and that OPN induced VEGF production, which indicated that OPN-VEGF axis might contribute to angiogenesis in nasal polyps PMID: 28716167
- Osteopontin and CD44 play important roles in the development and progression of meningioma and can be used as prognostic markers for tumor recurrence and progression as well as therapeutic targets for the development of new drugs. PMID: 29504367
- OPN play a role in pathogenesis of neurodegenerative diseases or in neuroprotection by regulating the activation and function of microglia. PMID: 28698867
- osteopontin has a role in DNA repair and impact on human glioblastoma radiosensitivity PMID: 27563812
- SPP1 promoted the metastasis of CRC. PMID: 28531945
- Results show that osteopontin is positively associated with hepatocellular carcinoma (HCC) metastasis, and that OPN can activate CCR1 expression through the PI3K/AKT/HIF-1a signaling pathway to promote HCC progression and metastasis. PMID: 29285854
- This review presents the current knowledge on the expression profiles of OPN and its main splice variants in human cancers, as well as the potential implications in patient outcome. [review] PMID: 28440483
- Strong correlations between the expression of type I, II, IV collagen and osteopontin and the clinical stage of tympanosclerosis indicate the involvement of these proteins in excessive fibrosis and pathological remodeling of the tympanic membrane. PMID: 29068597
- result of this study confirms that increased levels of OPN exist in CSF and peripheral blood of MS patients and strengthens the evidence regarding the clinical utility of OPN as a promising and validated biomarker for MS PMID: 29346446
- OPN overexpression was correlated with poor overall survival and clinical features reflecting high aggressiveness in patients with gastric cancer. PMID: 27626167
- ITGbeta3 and CD44 expression levels determine whether OPN-a inhibits or enhances growth in lung cancer cells. PMID: 27487131
- Study identified that miR-127-5p targets the 3' UTR of osteoarthritis (OA) mRNA to down-regulate the expression of OPN. In OA, the down-expressed miR-127-5p allows the expression of OPN, which mediates the establishment and development of OA. PMID: 27126955
- Our study shows a strong effect of the rs28357094 G allele in increasing osteopontin expression in the presence of deflazacort, and adds to the evidence that rs28357094 polymorphism may predict response to glucocorticoids in Duchenne muscular dystrophy. PMID: 28595270
- we described the expression pattern of osteopontin splice variants in papillary thyroid carcinoma samples and the key role of osteopontin-a expression on activating tumor progression features PMID: 27409830
- In Osteoarthritis tissues, OPN mRNA, and NEAT1 expression was upregulated, whereas miR-181c expression was downregulated, indicating that targeting NEAT1 to rescue miR-181c expression so as to inhibit OPN expression and synoviocyte proliferation PMID: 28379604
- IL-6 and sIL-6R induced by IL-1beta may trigger IL-6 trans-signaling, contributing to the upregulation of OPN in THP-1 macrophages. Macrophages may be used as a source of IL-6 and sIL-6R and evoke IL-6 trans-signaling. PMID: 27863335
- OPN is a key mediator of intracerebral tumor growth, invasion, and dissemination in central nervous system lymphoma, and these effects depend upon activation of NF-kappaB. PMID: 27050077
顯示更多
收起更多
-
亞細胞定位:Secreted.
-
蛋白家族:Osteopontin family
-
組織特異性:Bone. Found in plasma.
-
數據庫鏈接:
Most popular with customers
-
-
YWHAB Recombinant Monoclonal Antibody
Applications: ELISA, WB, IHC, IF, FC
Species Reactivity: Human, Mouse, Rat
-
Phospho-YAP1 (S127) Recombinant Monoclonal Antibody
Applications: ELISA, WB, IHC
Species Reactivity: Human
-
-
-
-
-